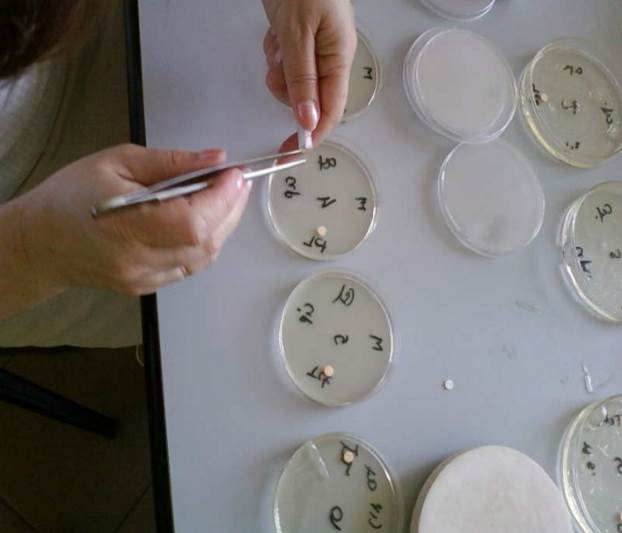

Int J Pharm Pharm Sci, Vol 6, Issue 7,189-191Original Article
EVALUATION OF ANTIFUNGAL ACTIVITY OF SATUREJA MONTANA ESSENTIAL OIL BEFORE
AND AFTER INCLUSION IN ΒETA-CYCLODEXTRINE
ENTELA HALOC I, VILMA TOSKA, ANNA BALDISSEROTTO, ENKELEJDA GOCI, SILVIA VERTUANI, STEFANO MANFREDINI
Entela Haloci, PhD student Ferrara University Italy, Pharmacy Department, Vilma Toska Pharmaceutical Department, Fakulteti i Farmacise, Tirane Albania, Department of Life Sciences and Biotechnology, Ferrara University, Italy, Enkelejda Goci Pharmaceutical Department, Aldent University, Tirana Albania, Stefano Manfredini Pharmaceutical Chemsitry, President of the School of Pharmacy Head of Pharmaceutical Department, Ferrara University, Italy. Email: entelahaloci@yahoo.com
Received: 27 Feb 2014 Revised and Accepted: 29 Mar 2014
ABSTRACT
Objective: The aim of this study is the evaluation of the antifungal activity of Satureja montana essential oil collected in north of Albania, and how it is affected by microencapsulation in β-cyclodextrin (β-CD).
Methods: GC/FID spectrometry analysis of the isolated oil was used. The antifungal activities of essential oil before and after microencapsulation were individually evaluated against following dermatophytes M.gypseum, M.canis, A.cajetani, T.violaceum, T.mentagrophytes, E.floccosum,T. Rubrum, T. tonsurans and phytopatogens B.cinerea and P.oryzae using a disc diffusion method.
Results: GC/FID analyses resulted in the identification of twentyone compounds in the oil of Satureja Montana essential oil. Carvacrol was the major constituent of the S. montana oil (around 60 %). Other important compounds were the monoterpenic hydrocarbons p-cymene, y- terpinene and the oxygenated compounds borneol. Maximum activity of Satureja montana oil was observed against T.violaceum, T. Rubrum, T. tonsurans, T.mentagrophytes and P.oryzae (inhibition zone > 70 %).
Conclusion: From the results is evident that microencapsulation does not change the antifungal activity of essential oil, this should consent to achieve the optimal antifungal activity with minimum side effects of essential oil, and improved stability upon storage due to benefits of microencapsulation in β-cyclodextrine. Moreover, after encapsulation improved activity were obtained (inhibition zone > 70)
Keywords: Satureja montana, Essential oil, Gas/Fid, Antifungal. Sustainability
INTRODUCTION
Fungal infection is very often occurring on these days. They are getting more and more resistant to antifungal agents which are very expensive ones and associated with by a several side effects. On the other hand traditional medicine is cheaper and more effective than modern medicine. Patients have a reduced risk to use herbal drugs than antifungal agents. is often less expensive and equally effective as compared to several drugs and sustainable, because it consent to preserve traditional recipes and folk medicine.
We choose Satureja montana as it is well-known for its essential oil contents and dermatological benefits. To expand its dermatological application we investigate the preparation of essential oil from samples collected in different zones of Albania, their antifungal activity and their inclusion in cyclodextrine complexes, in order to achieve better stability and better compatibility with skin application. The present study was conducted to compare the antifungal properties before and after encapsulation of the essential oil. The ratios of oil: beta-cyclodextrine used is 20:80 and 10:90 (w/w).
MATERIALS AND METHODS
Plant Material
Herbal plants of Satureja montana were collected from different zones of Albania and were identified from our botanist at the Botanic Department, University of Tirana, Albania. Sample of drug is recorded in Herbarium Deposit in University of Tirana.
Isolation of the essential oil
The hydrodistillation was carried out with a Clevenger-type apparatus according to the Hungarian Pharmacopiea VII. (1986). A Drug quantity of 20 g was used, it was distilled with 500 ml of water for 3 hours. The resulting essential oil was dried over anhydrous sodium sulphate and stored at 4°C. [2,16,10]
Reagents
All reagents and solvents used were obtained from Sigma Aldrich Company. Gas/Fid TipVarian CP3800, Stationary, Phase Capilar VF: 1ms, Film thikckness 0.25 µm (L) 25 mx (ID) 0.25 mmx (OD) 0.39 mm. Mobile Phase is helium. Standarts of carvacrol, p-cymen, y-terpinen, borneol, thymol were obtaind from Sigma Aldrich company. beta-Cyclodextrin was purchased from Titolchimica (Italy).
Fungal Strains
Fungal strains were developed by Dipartimento di Scienze della Vitae Biotecnologie, University of Ferrara. Dermatophytes: The dermatophytes used were Arthroderma cajetanum (Netherlands), CBS 495.70 strain; Epidermophyton floccosum var. floccosum (Netherlands) CBS 358.93 strain; Trichophyton violaceum (Africa) CBS 459.61 strain; Trichophyton tonsurans (Netherlands) CBS 483.76 strain; Trichophyton mentagrophytes (Netherlands) CBS 160.66 strain; Microsporum canis (Iran) CBS 131110 strain; Trichophyton rubrum (Turkey) CBS 132252 strain; Microsporum gypseum (Iran) CBS 130948 strain; the phytopatogens used were Botrytis cinerea (Netherlands) CBS 1798.71 strain; Pyricularia oryzae (unknown) CBS 433.70 strain; obtained from CBS-KNAW Fungal Biodiversity Centre, An institute of the Royal Netherlands Academy of Arts and Sciences, Utrecht, Netherlands. The cultures were maintained in the laboratory as agar slants on a suitable culture medium, that is, on Sabouraud dextrose agar (SDA; Difco), for the dermatophytes and on Potato dextrose agar (PDA) for phytopatogens.
Gas/Fid method
Gas/Fid conditions GC analysis of the essential oil was performed using a Varian CP-3800 instrument equipped with a capillary column. Helium was used as the carrier gas at the constant flow of 1.2 ml/min and split ratio 1:30. The oven temperature was held at 50 °C for 1 min, then programmed to 280°C at a rate of 5°C /min. Helim flux is 30ml/min and air fluks is 300ml/min. The injector temperature is 280 and detector (FID) temperature is 300°C. Injection volum is 1μl. [3]
Antifungal Activity
The essential oil samples before and after encapsulation were tested for antifungal activity by the disc diffusion method using 100µL of suspension of the tested fungal strains containing 2.0x105 spore mL–1 colony Mueller--Hinton agar and dextrose agar were distributed to sterilized Petri dishes with a diameter of 9 cm. Fig 2. The filter paper discs (6 mm in diameter) were individually impregnated with 20µL and 100µL of the essential oils dissolved in dimethylsulfoxide (DMSO). The Petri dishes were kept at 4°C for 2 h.
The plates inoculated with dermatophytes were incubated at 30°C for 7 days and plates incubated with phytopatogens were incubated at 30°C for 5 days. The diameters of the inhibition zones were measured in millimeters.
Controls were set up with equivalent quantities of DMSO [3,15,18,20].
Tab 1: It shows the inhibition growth of Satureja montana essential oil to dermatophytes and phytopatogens
| % Inhibition of Growth | ||||
| Dermatophytes | Satureja montana | S.montana-β CD 10:90 | S.montana-β CD 20:80 | |
| M. gypseum | 20 µg/ml | 18.56 | 33.67 | + |
| 100 µg/ml | 76.29 | 81.63 | 37.25 | |
| M. canis | 20 µg/ml | 1.80 | 7.69 | 9.78 |
| 100 µg/ml | 36.94 | 95.60 | 18.48 | |
| A. cajetani | 20 µg/ml | 4.84 | 26.23 | 0.00 |
| 100 µg/ml | 12.90 | 40.98 | 6.56 | |
| T. violaceum | 20 µg/ml | 28.57 | 23.33 | 10.34 |
| 100 µg/ml | 100.00 | 100.00 | 34.48 | |
| T. mentagrophytes | 20 µg/ml | 4.35 | 23.46 | + |
| 100 µg/ml | 77.17 | 100.00 | 9.59 | |
| E. floccosum | 20 µg/ml | -12.50 | 17.86 | + |
| 100 µg/ml | 37.50 | 89.29 | ++ | |
| T. rubrum | 20 µg/ml | 12.90 | 44.44 | + |
| 100 µg/ml | 93.55 | 100.00 | 41.67 | |
| T. tonsurans | 20 µg/ml | 4.76 | 17.86 | 3.13 |
| 100 µg/ml | 83.33 | 92.86 | 6.25 | |
| Phytopatogens | ||||
| B.cinerea | 20 µg/ml | 5.16 | -0.31 | 0.00 |
| 100 µg/ml | 14.68 | 58.49 | 3.80 | |
| P.oryzae | 20 µg/ml | 13.68 | 44.44 | 3.08 |
| 100 µg/ml | 42.11 | 92.59 | 21.54 |
Studies were performed in triplicate. In addition, as negative controls is used DMSO.
Table 2: It shows Gas/Fid results of Satureja montana essential oil major components
| Farmaci Popullore (M1) | Kerrabe (M2) | Kruja (M3) | Elbasan (M4) | |
| p-cymen | 20.86 | 5.9 | 11.04 | 9.61 |
| y-terpienen | 2.05 | 8.45 | 3.07 | 2.86 |
| borneol | 0 | 0.2 | 0.67 | 4.76 |
| thymol | 6.2 | 18.2 | 3.94 | 25.78 |
| carvacrol | 6.11 | 67.68 | 46.18 | 64.22 |
Fig. 1: It shows inoculation of pregnated disks of Satureja montana essential oil.
DISCUSSION
Satureja montana essential oil had considerable inhibitory effects on following fungis Microsporum gypseum, Mycrosporum.canis, Nannizzia cajetani, Tricholosporum violaceum, Trichophyton mentagrophytes, Epidermophyton floccosum, Trichophyton rubrum, Trichophyton tonsurans and Phytopatogens, Botrytis cinerea and Pyricuhria oryzae expecially M.gypseum 76.29 %, T. mentagrophytes 77.17%, T.tonsurans (83.33%), T.rubrum (93.55%), and T.violaceum (100 %). The inhibition zones of essential oil after encapsulation are considerably higher to those encapsulated in β-cyclodextrine.
This means that the encapsulation process does not impair the antifungal activity of Satureja montana essential oil. On the other hand the slow releasing of essential oils from β-cyclodextrine complex causes higher inhibition zone sometime the highest one (100 %). Table 1 shows that sample M3 and M4 (Table 2) having high levels of carvacrol (66.22, 67.68) and thymol (18.2, 25.78) also display higher inhibition zone than other samples. On the other hand the inhibition zone of essential oil after encapsulation are very closed to those before encapsulation as stated above, this is an important finding to enlarge potential application of the antifungal properties of Satureja montana essential oil.

Fig. 2: It shows Gas/Fid chromatogram of Satureja montana (M1)
Furthermore, this occurrence can be explained by longer time of contact with fungis due to the slower release of the oil. Moreover, as shown in Table 1, the ratio oil/β-cyclodextrine10:90 has higher inhibition zone than the ratio 20:80. The solubility of essential oil at these ratios, maybe at the base of the observed activity, thus so we suggest as optimal ratio 10:90. However, the improvements on antifungal activity and physic-chemical stability of microencaspultaion of essential oil in β-cyclodextrine have been clearly demostrated in this study. Another important consideration relates to range of concentrations: concetrations below 20 μg/ml are devoid of antifungal activity and on the other hand there is no need to use concentrations over 100μg/ml.
CONCLUSION
Satureja montana essential oils with high concentration of carvacrol and thymol are the most effective against fungis taken into consideration in this study. Microencaspulation of essential oil in beta-cyclodextrine rather than decreasing, improves the antifungal properties of Satureja montana essential oil. As a final consideration emerging from the study, antifungal activity ranges are easily achieved between 20 and 100 μg/ml and incapsulation should infere better tolerability to Satureja montana oil thus extending ranges of application and possible industrial application to the pharmaceutical/nutritional/cosmetic fields. Further study are currently ongoing to assess formulation in finished product and tolerability studies in humans and in vitro.
CONFLICT OF INTERESTS
Declared None.
ACKNOWLEDGEMENTS
Authors are thankful to Tirana University, Ferrara University, National Drug Control Laboratory of Albania, S.M. whish to thank, Ministry of Education, University and Research (MIUR Italy) (PRIN, Grant 20105YY2HL_006) the University of Ferrara (grants FAR 2011, 2012, 2013) and Ambrosialab srl, Ferrara for the financial support
REFERENCES
- Carol USA, Stream IL. Identification of essential oil components by gas chromatography andmass spectroscopy.
- Gulluce M, Sokmen M, Daferera D, Agar G, Ozkan H, Kartal N, et al. In vitro antibacterial, antifungal, and antioxidant activities of the essential oil and methanol extracts of herbal parts and callus cultures of Satureja hortensis L. J Agric Chem 51;2003:3958-65.
- Bezi N. Sko^Ibu[I], M., Dunki], V., Antimicrobial effect of Satureja cuneifolia Ten. essential oil Acta Bot Croat 58;1999:99-104..
- Cazin, C., Jonard. R., Alain, P., Pellecuer, J., 1985:Levolution de la composition des essentieles chez divers chemotypes des Sarriette des montangnes (Satureja Montana L.) obtenus par lisolement in vitro des apex. CR Acad. Sc., Paris. 6, 237–240. 320 ACTA BOT. CROAT. 64 (2), 2005
- Escudero, J., Lopez, J. C., Rabanal, R. M., Valverde, S., 1985:Secondary metabolites form Satureja species-new triterpenoid from Satureja-Acinos. J. Nat. Prod. 48, 128-–132.
- Gulluce, M., Sokmen, M., Daferera, D., Agar, G., Ozkan, H., Kartal, N., Polissiou, M., Sokmen, A., Sahin, F., 2003:In vitro antibacterial, antifungal, and antioxidant activities of the essential oil and methanol extracts of herbal parts and callus cultures of Satureja hortensis L. J. Agric. Chem. 51, 3958–3965.
- KuTrak D, Kuftinec J, BlaEvi N, Maffei M. Comparison of the essential oil composition of two subspecies of Satureja montana. J Essent Oil Res 11;1996:7-13.
- Milo [, M., Radoni], A., Bezi], N., Dunki], V.::Localities and seasonal variations in the chemical composition of essential oils of Satureja montana L. and Satureja cuneifolia Ten Flav Fragr J 16 ACTA BOT CROAT 321 2005;64(2):157-60.
- Helander IM, Alakomi HL, Latva-Kala K, Mattil-Sandho T, Pol I, Smid EJ, et al. Characterization of the action of selected essential oil components on Gram-negative bacteria. J Agric Food Chem 46;1998:3590-5.
- Sivropoulou A, Papanikololau E, Nikolaou C, Kokkini S, Lanaras T, Arsenakis M. Antimicrobial and cytotoxic activities of oreganum essential oils. JAgric Food Chem 44;1996:1202-5.
- Sko^Ibu[I], M., Bezi], N., Chemical composition and antidiarrhoeal activities of winter savory (Satureja montana L. essential oils Pharm Biol 41;2003:622-6.
- Sko^Ibu[I],M., Bezi], N., Dunki], V., Variability of Satureja cuneifolia Ten. Essential oils and antimicrobial activity depending on the stage of development Eur Food Res Technol 218;2004:367-71.
- Sko^Ibu[I], M., Bezi], N., Chemical composition and antimicrobial variability Satureja montana L. essential oils in the ontogenesis J EssentOil Res 16;2004:387-91.
- Smith-Palmer A, Stewart J, Fyfe L. Antimicrobial properties of plant essential oils and essences against five important food-borne pathogens. Lett Appl Microbiol 1998;26(2):118-22.
- Tümen G, Kirimer N, Ermin N, Başer KH. The essential oil of Satureja cuneifolia. Planta Med 1998;64(1):81-3.
- Dool H, Kratz PD. Van Den Ageneralization of the retention index system including linear temperature. Journal of nanoscience and nanotechnology;1963.
- Stefano H, Silvia T, Irma Z. Entela Vilma Paola Henri Kolani-Antibacterial and Antifungal Activity Assesment of Nigella Sativa Essential Oils-World Academy of Science, Engineering and Technology 66 pg. Journal of nanoscience and nanotechnology;2012:1198-200.
- Stefano H, Silvia T, Montana L. Entela Vilma Paola Ziosi,-Characterization, antibacterial activity assesment and inclusion in CD of Satureja essential oils, Europian Journal of Pharmaceutical sciences ISSN pg 168. Journal of nanoscience and nanotechnology:0928-87.
- Ibraliu A, Mi X, Dajic SZ, Shehu J. Ristić M, Analysis of essential oils of three wild medicinal plants in Albania. J Med Plants Res 2011;5(1):58-62
- Mathur, G.B.K.S. Prasad, V.K. Dua, Flora and Fauna, 2010, 16, 281-85.
- Mathur, V.K. Dua, G.B.K.S Prasad, Int. Journal Chem. Env. Pharm. Res., 2010, 1(1), 12-16.
- Mathur, S.K. Verma, S.K. Singh, G.B.K.S Prasad, V.K. Dua, J. Pharmacogonasy and Herbal Form., 2010, 1(1), 1-7.
- Mathur, G.B.K.S. Prasad, V.K. Dua, Int. J. Pharm. Biosciences., 2011, 2(1), 541-44.
- Mathur, S. Yousuf, S.K. Verma, S.K. Singh, G.B.K.S. Prasad, V.K. Dua, Int. J. Pharm.Biosciences., 2011, 2(1), 545-48.
- Mathur, R. Purohit, D. Mathur, G.B.K.S Prasad, V.K. Dua, Der Chemica Sinica, 2011,2(1), 174-81.
- Mathur, R. Purohit, D. Mathur, G.B.K.S Prasad, V.K. Dua, Der Pharmacia Sinica, 2011.
- Pina-Vaz C, Gonçalves Rodrigues A, Pinto E, Costa-de-Oliveira S, Tavares C, Salgueiro L, et al. Antifungal activity of Thymus oils and their major compounds. Journal of the European Academy of Dermatology and Venereology:JEADV 2004;18(1):73-8.